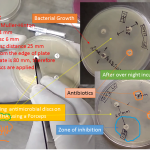
Muller Hinton agar(MHA) uses AST method Kirby-Bauer Method

Category: medical
Mueller Hinton Agar (MHA): Introduction, Composition, Preparation and Its Applications
History and Introduction of Mueller Hinton Agar The name Mueller...
History and Introduction of Mueller Hinton Agar The name Mueller...
E-Test (Epsilometer Test): Introduction, Principle, Procedure, Result and Interpretation
 Introduction of Epsilometer test (E-test) Epsilometer test is in brief E-test....
Introduction of Epsilometer test (E-test) Epsilometer test is in brief E-test....
Culture media: Introduction, Composition and Types
 Introduction of culture media Media –Plural While medium is singular...
Introduction of culture media Media –Plural While medium is singular...
